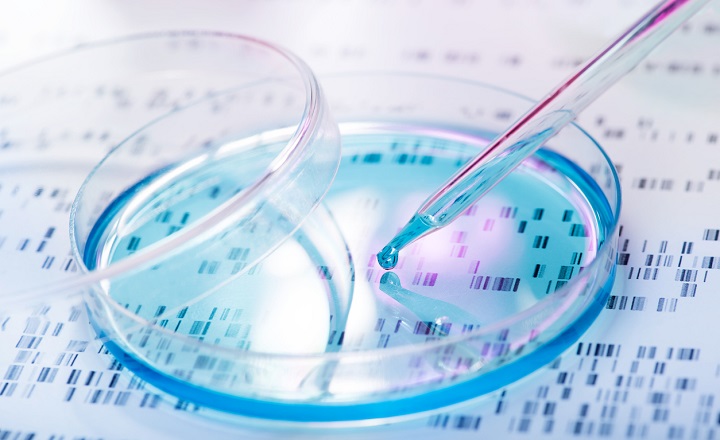

Effects of biotechnology on quality of raw materials, nutrition, and process in food industry; application of biotechnology methods and techniques in fermentation technology, enzyme technology, genetic engineering, protein engineering, and bioprocess engineering for modifying food components to improve or get new valued products; methods to increase effective production process and analyze food components; presentation relating to current topics in food biotechnology.
- Teacher: Pochanart Kanjan
- Teacher: SUPPASIL MANEERAT
- Teacher: Aem Nuylert